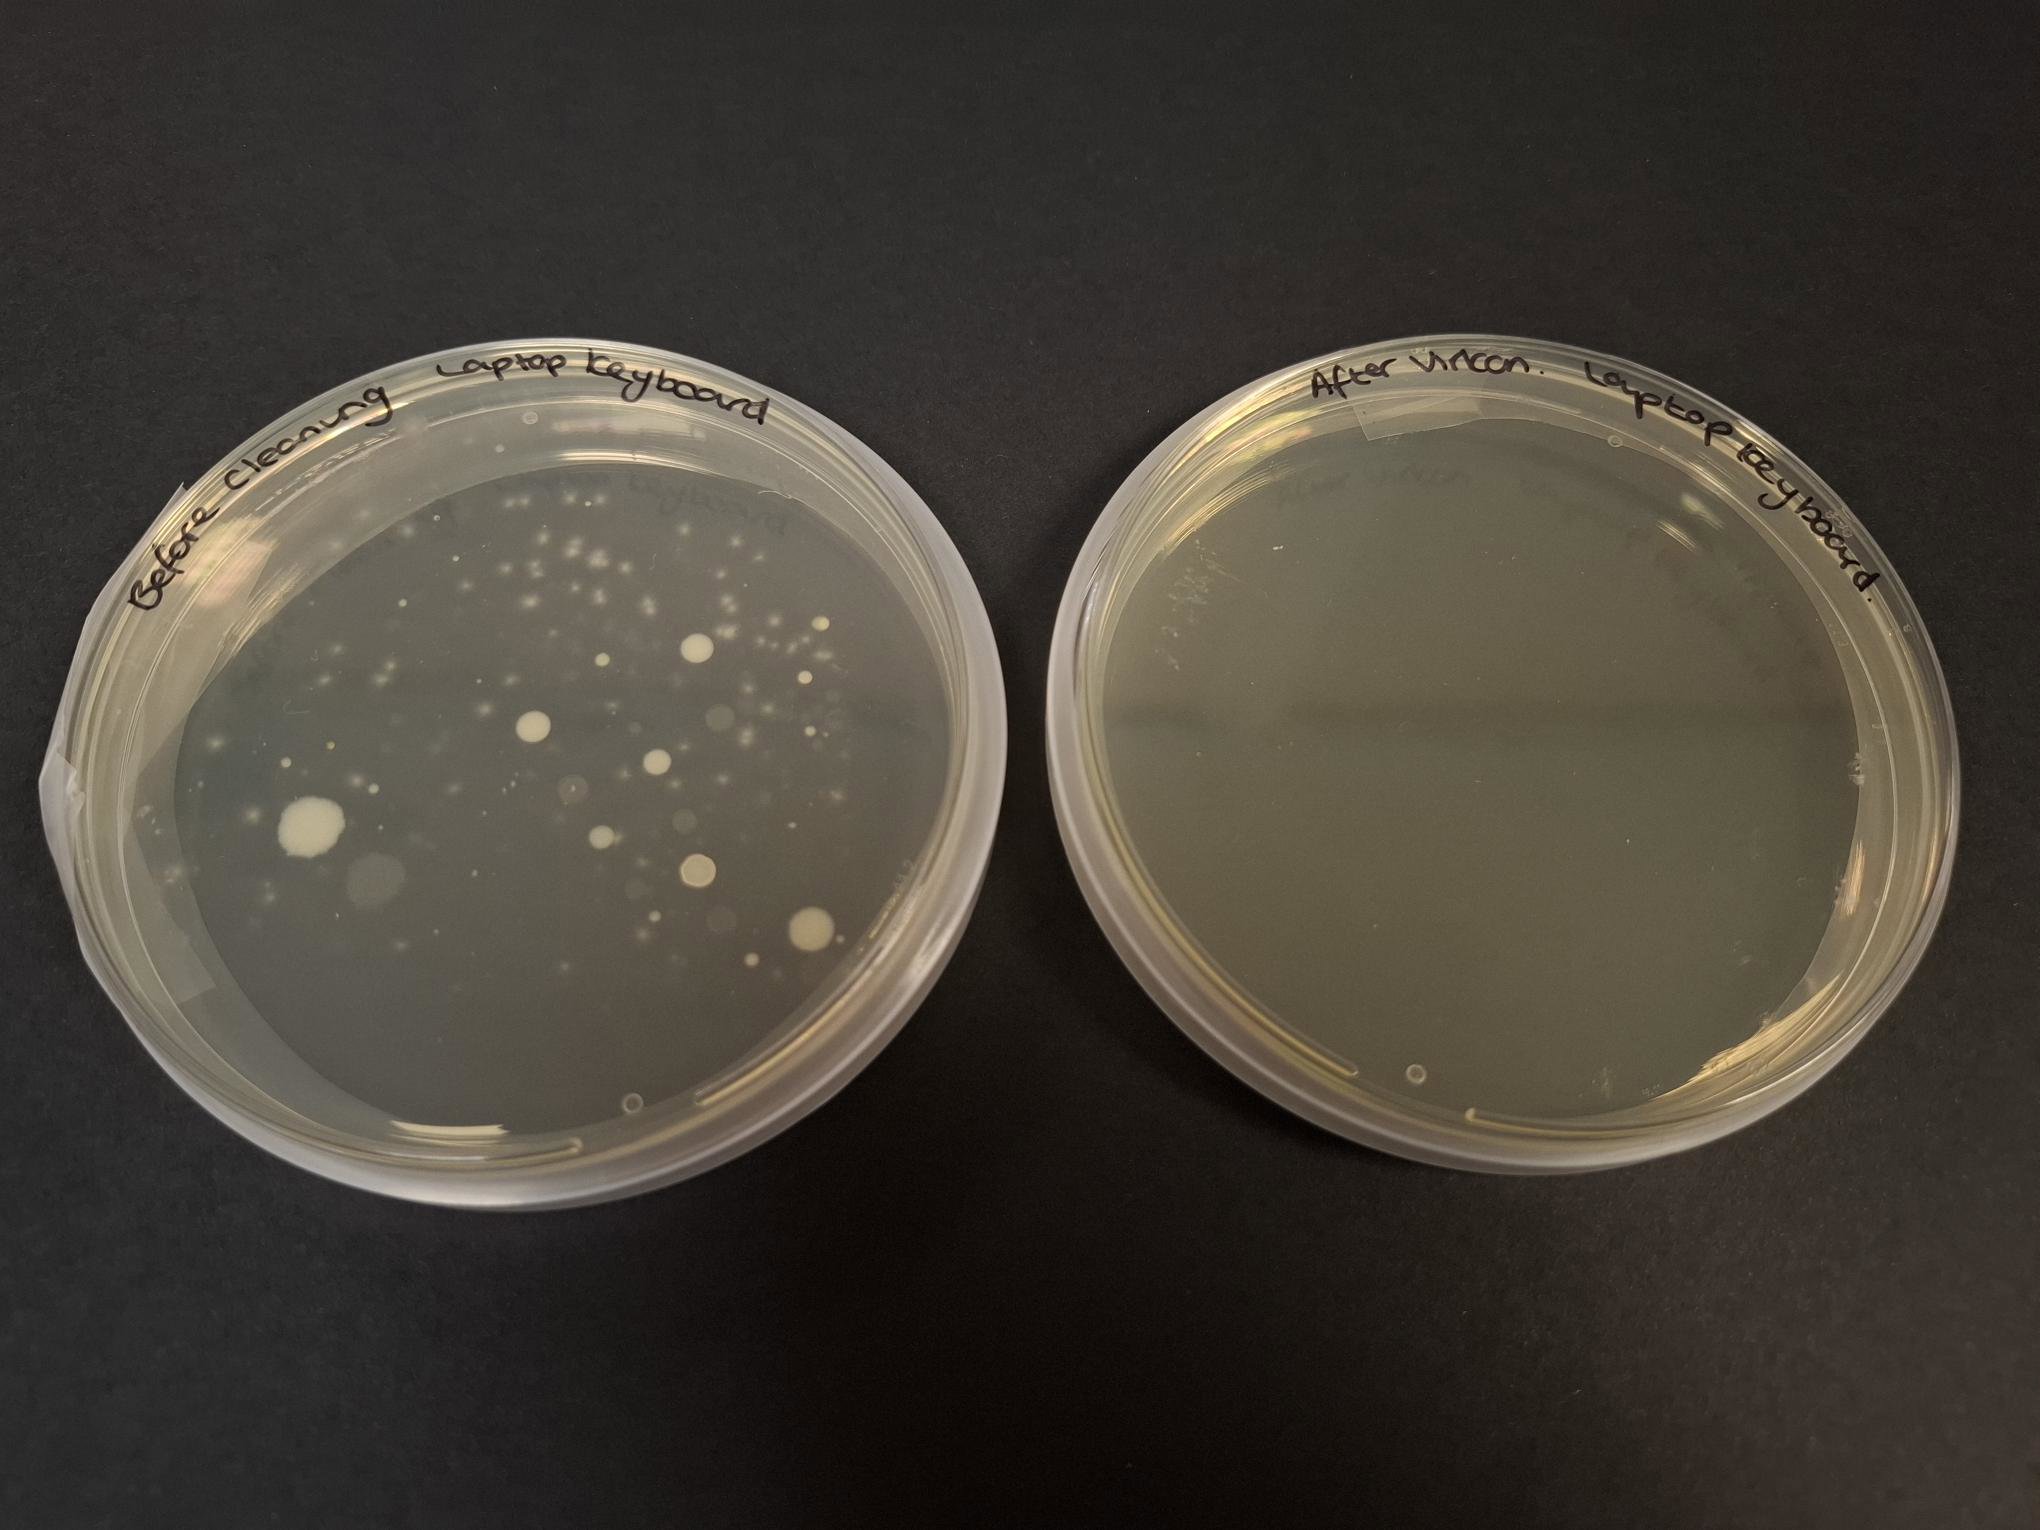

Bronze Award
Typical ages 11+
Typically 10 hrs
£6 UK; £12.50 International; per student
An introduction to STEM project work for 11+ year olds working individually or in teams. Bronze Awards develop research skills and allow student to work like real scientists, technologists, engineers or mathematicians. Students can design their own project, or use one of our free project resources and workbooks to kick start their thinking and keep their work on track.

How to run
Plan
Browse the free resources in our Resource Library for Bronze project ideas.
Alternatively, students can create and design their own Bronze projects. Familiarise your students with the CREST criteria for Bronze so they know what to aim for.
Complete
Students complete their Bronze projects before submission. Create a free account on our application platform to submit projects.
Upload a sample of the Bronze project work or a completed Bronze workbook.
Assess
Students must meet at least 11 of the 15 Bronze CREST criteria to earn a Bronze CREST Award.
A teacher or adult assesses the Bronze projects.
Achieve!
Celebrate the success of your students as they achieve their Bronze CREST Awards.
Share your experience with us - email us, tell us in the survey, or tag us in your posts. Let's spread the joy and inspire others with your students' success!
Free Bronze resources
- This Bronze project asks students to explore which methods are best for revealing fingerprints on different types of surface.#Bronze#Materials#Chemistry#Crime
- This Bronze project has been designed and adapted for students with SEND. This teacher guide will support you to run the 10 hours of project work needed for your students to achieve a Bronze CREST Award. It comes with...#Materials#Food#SEND
- These supporting slides are designed with the needs of students with SEND in mind and accompany the Bronze Award teacher guide, student workbook and Widgit pack. Together, the resources provide everything you need to...#Materials#Food#SEND
- This Bronze project allows students to study materials and the ways they can break in different ways. Can they work out the cause of a break by looking at the pieces?#Materials#Physics#Crime
- This Bronze project asks students to investigate and find the best recipe for homemade bath bombs.#Bronze#Home#Chemistry#Engineering#D&T
Fees and funding
The Bronze CREST Award costs £6 per student. While we want all young people to participate, we recognise that costs can be a barrier for some schools. UK schools in challenging circumstances, especially those with many underrepresented pupils in STEM, can apply for funding to help run CREST.

Hear from our community



"There was a definite buzz through the room of people discovering things all the time and feeling that they knew more about it, and that was sort of throughout that they were getting that. You wouldn’t have the sustained interest and enthusiasm without that. The feeling in the classroom was of people discovering things. "



"I feel like they’re more independent, they’re happier to take risks, they’re happier to design their own experiments, they’re happier to fail."



"I delivered the Bronze CREST Award to my SEND pupils as part of their STEAM Club. I was really pleased with how engaged they were and how accessible the project work was for them. This has helped their potential to shine and for them to celebrate a successful project outcome. In turn, the profile of Science and the STEAM Club has been raised too."
Need inspiration?

Apply for a Bronze Award
Other CREST Awards for Secondary levels

Typical ages 10-14
Typically 5 hrs
£3 UK; £7.50 International; per pupil
Discovery Award
A STEM project that can be done in one day, perfect for encouraging your students to explore student-led work. Develop your students' communication, problem solving and teamwork skills.
Explore Discovery Award
Typical ages 14+
Typically 30 hrs to complete
£15 UK; £25 International; per student
Silver Award
Challenge your students to take ownership of a STEM project in teams or individually. Silver Awards are designed to stretch students and enrich their STEM studies. Whether investigating their own project idea or using one of our free resource prompts, students plan and direct their own project, gaining in-depth experience of the scientific method or engineering design process.
Explore Silver Award
Typical ages 16+
Typically 70 hrs to complete
£30 UK; £40 International; per student
Gold Award
Awaken your students’ potential with a long-term, open-ended project ideal for enhancing their UCAS applications. Gold Awards are longer projects that immerse students in real research. At this level, we recommend students work with a mentor from their chosen STEM field of study.
Explore Gold Award

We are here to help
Find answers to your questions quickly and easily with our Help Centre Frequently Asked Questions (FAQs). Whether you're just getting started with CREST Awards or looking for specific details on projects, resources, or submission guidelines, our comprehensive FAQs has you covered.